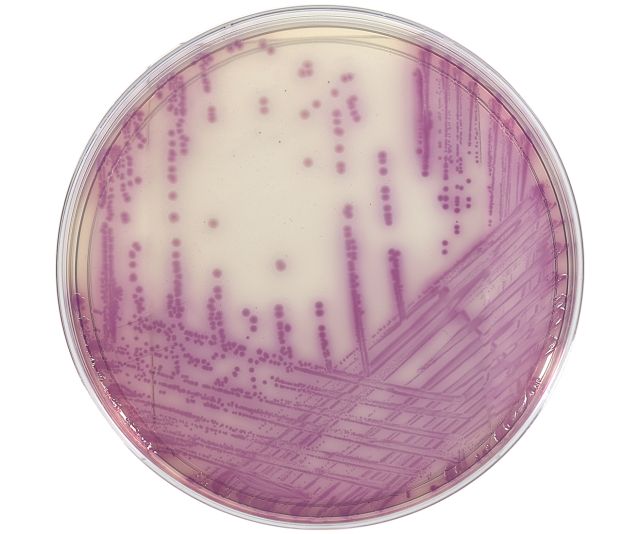

Hardy Diagnostics
HardyCHROM Salmonella, Chromogenic Medium, 15x100mm Plate. 10 per package
HardyCHROM Salmonella, Chromogenic Medium, 15x100mm Plate. 10 per package
Couldn't load pickup availability
HardyCHROM™ Salmonella is a differential medium that facilitates the isolation and differentiation of Salmonella spp. from other members of the family Enterobacteriaceae.
This medium utilizes the ability of Salmonella spp. to produce acid from propylene glycol. This characteristic is used in conjunction with a chromogenic indicator to differentiate Salmonella spp. form Proteus spp. and other Enterobacteriaceae.
Salmonella spp., including S.typhi and S.paratyphi A, produce pink to magenta colonies as a result of propylene glycol utilization. Members of the family Enterobacteriaceae produce blue, blue-green, white, or colorless colonies, while Gram-positive bacteria and non-glucose fermenting bacteria will be inhibited.
Share